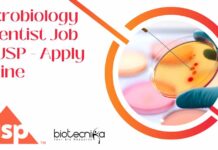
Microbiology Scientist Job at USP – Apply Online Microbiology Scientist Job at USP

12+ TIGS Life Sciences Project Research Jobs – Apply Online
TIGS Life Science Project Research Jobs - Apply Online
TIGS Life Science Project Research Jobs - Apply Online. Interested and eligible applicants can check out...
CSIR-IICB MSc Biotech Non-NET Project Vacancy – Apply Now
IICB MSc Biotech Non-NET Project Vacancy - Apply Now
Advertisement No. : R&C/579/2025
Date of Advertisement: 04/01/2025
Vacancy Code: 5792516
Position: Project Associate-I
No. of Vacancies: 1
Walk-in Interview on:...
Project JRF Position For MSc, MTech at Regional Centre for Biotechnology, Apply Online
RCB Project Positions 2025 - MSc, MTech Apply Online
Advt. No. 05/Project/2025/HR
Interview for ‘Project-JRF’ Position
Title of Project: Genetic and translational landscape of Candida glabrata pathogenesis...
Govt BSc Life Sciences Jobs at Tea Research Association, Attend Walk-In
Govt BSc Life Science Jobs at Tea Research Association, Attend Walk-In
Tea Research Association
Situation Vacant
Advertisement No.: 3622/TOK/G.25/1001
Date: 31st January, 2025
Positions Available under the Bomlife Pvt....
Sanofi Life Science Analyst Job Opening – Apply Online
Sanofi Life Science Analyst Job Opening - Apply Online
Analyst - Transparency Reporting
Location: Hyderabad
Time Type: Full-time
Posted On: Posted 7 Days Ago
Time Left to Apply: End...
Microbiology Scientist Job at USP – Apply Online
Microbiology Scientist Job at USP - Apply Online
Scientist II, Microbiology
Location: Hyderabad, IND
Job Category: Publications
Job Type: Full-Time
Req ID: SCIEN00262
Description
Brief Job Overview:
This is a hands-on, non-supervisory...
Beckman Coulter Life Sciences Development Scientist Job For Cell Biology, Apply Online
Beckman Coulter Development Scientist Job For Cell Biology, Apply Online
Development Scientist I (Bangalore)
Company: Beckman Coulter Life Sciences
Location: Bangalore, Karnataka, India
Category: Science
Job Id: R1280584
Do you...
Scientist Position Available at Cytiva – MSc Life Science & Microbiology Apply Online
Scientist Position at Cytiva - MSc Life Science & Microbiology Apply Online
Scientist I, Bangalore
Company: Cytiva
Location: Karnataka, India
Category: Science
Job Id: R1280857
The Scientist I for Cytiva...
Research Technician Job at Beckman Coulter Life Sciences! Apply Now!
Research Technician Job at Beckman Coulter Life Sciences! Apply Now!
Research Technician-II (Location - Bangalore)
Company: Beckman Coulter Life Sciences
Location: Bangalore, Karnataka, India
Category: Science
Job Id: R1282892
Do...
Danaher Corporation IP Analyst Job – Apply Now!
Danaher Corporation IP Analyst Job - Apply Now!
Intellectual Property Intelligence Analyst
Danaher Corporation, Bangalore, Karnataka, India
Category: Legal | Job Id: R1283595 | Location: Bangalore, Karnataka,...
CSIR-IMTECH Non-NET Project Vacancy – Applications Invited Online
CSIR-IMTECH Non-NET Project Vacancy - Applications Invited Online
CSIR‐INSTITUTE OF MICROBIAL TECHNOLOGY
Sector 39‐A, Chandigarh‐ 160036
ROLLING ADVT. NO. 2025‐01‐04
Project titled: “MitoInfect: An integrative Approach to Dissect...
Microbiology Executive at Sanmed Healthcare – BSc & MSc Apply Online
Microbiology Job at Sanmed Healthcare - BSc & MSc Apply Online
Microbiology Executive
Sanmed Healthcare
Location: Hyderabad
Employment Type: Full-Time
Experience Level: Executive (2 to 4 years)
Salary: ₹3L -...
Why Clinical Research Is One of the Best Career Choices in 2025?
Is Clinical Research a Good Career in 2025? Here’s Why It’s Booming
The field of clinical research plays a crucial role in advancing healthcare by...
CSIR-CCMB Summer Training Program 2025 – Applications Invited Online
CSIR-CCMB Summer Training Program 2025 - Applications Invited Online
Summer Training Program 2025
CSIR-Centre for Cellular and Molecular Biology, Hyderabad (CSIR-CCMB) invites online applications for the...
IISER Pune Summer Student Programme 2025 – Applications Invited
IISER Pune Summer Student Programme 2025, Apply OnlineThe Online Registration For The Programme Will Be Open During 1st - 21st February
IISER Pune invites applications...